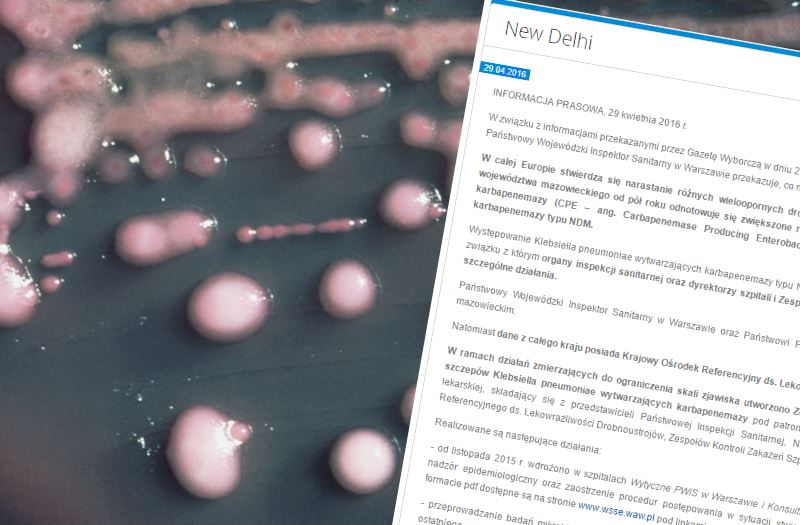
Bakteria Klebsiella pneumoniae. Fot. domena publiczna

Lekooporna superbakteria w Warszawie. Sanepid potwierdza
W szpitalach w Warszawie rośnie liczba zakażonych bakterią New Delhi, odporną na antybiotyki – informuje Gazeta Wyborcza. Sanepid potwierdza te informacje i wydaje komunikat.
Bakterią zarazić się bardzo łatwo. Wystarczy np. skorzystać z tej samej toalety, co nosiciel. Na artykuł w „Wyborczej” zareagowała wojewódzka Stacja Sanitarno-Epidemiologiczna w Warszawie:
„Wśród niektórych szpitali warszawskich oraz kilku szpitali województwa mazowieckiego od pół roku odnotowuje się zwiększone rozprzestrzenianie pałeczek jelitowych Enterobacteriaceae produkujących karbapenemazy (CPE – ang. Carbapenemase Producing Enterobacteriaceae), w tym szczepów Klebsiella pneumoniae wytwarzających karbapenemazy typu NDM.” – pisze WSSE – „Obserwowany na początku 2016 r. wzrost liczby pojedynczych przypadków jak i zgłaszanych ognisk epidemicznych może sugerować nie tylko zwiększenie rozmiarów problemu, ale także wzmożoną czułość prowadzonego obecnie nadzoru, min. z powodu wykonywania zwiększonej liczby badań mikrobiologicznych i rejestrowanie zarówno przypadków bezobjawowej kolonizacji jak i objawowych zakażeń. Dalszą analizę umożliwi prowadzony w sposób ciągły monitoring sytuacji oraz współpraca z Dyrektorami szpitali i kontynuowanie działań zgodnych z wytycznymi.” – stwierdza Maria Pawlak, Państwowy Wojewódzki Inspektor Sanitarny w Warszawie, Przewodnicząca Zespołu ds. ograniczania rozprzestrzeniania się NDM na Mazowszu.
WSSE podjęło też szereg środków zabezpieczających m.in. wzmożone kontrole, szkolenia personelu szpitalnego, a także badania punktowe:
„WSSE w Warszawie we współpracy z KORLD w styczniu 2016 r. przeprowadziła badania punktowe w ok. 20% szpitali woj. mazowieckiego,którymi objęto ok. 2 tys. pacjentów, i stwierdzono ok. 2,4 % wyników dodatnich.”
Redaktor naczelny portalu. Absolwent Dziennikarstwa i Nauk Politycznych Uniwersytetu Warszawskiego. Zawodowo interesuje się prawem i ekonomią.